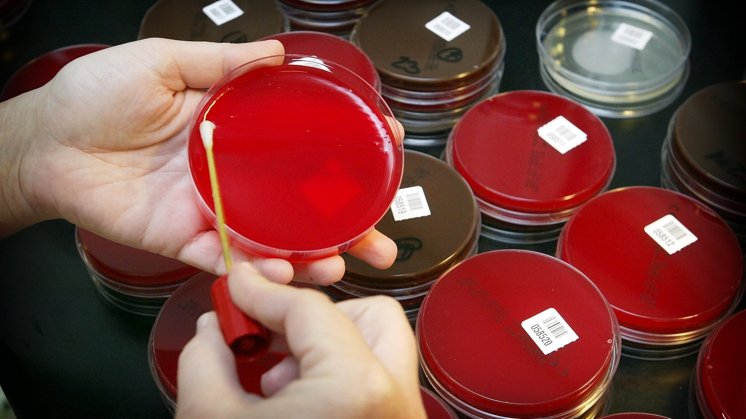
Arkivfoto: Henrik Bo

Tarmstudie vækker bekymring
Hver tredje dansker bærer rundt på antibiotikaresistente bakterier i tarmen. Situationen bekymrer forskere og kan føre til adskillige dødsfald
- Vi har ikke det fulde overblik over omfanget af problemet, men jeg tør godt sige, at mindst en tredjedel af den danske befolkning render rundt med bakterier i tyktarmen, som er resistente over for en eller flere typer af antibiotika, siger Ulrik Stenz Justesen, som er overlæge, klinisk lektor og ekspert i resistens blandt tyktarmens bakterier.
Problemet opstår, når de modstandsdygtige bakterier slipper fri fra tyktarmen i forbindelse med for eksempel en operation eller blindtarmsbetændelse. Når bakterierne først er undsluppet tarmens beskyttende vægge, kan de nemlig snige sig andre steder hen i kroppen og give anledning til en infektion, som i værste fald kan slå patienten ihjel, fordi den ikke kan dræbes med antibiotika.
Læs mere på Videnskab.dk: MRSA og andre ’dræberbakterier’ - skal vi nu være bange?
- Frem til 1980’erne så vi slet ikke resistens i bakterierne i tyktarmen. Nu ser vi det mere og mere både i Danmark og andre lande. Det er rigtig bekymrende, siger Ulrik Stenz Justesen, som er i færd med at kortlægge resistensudviklingen blandt tyktarmens bakterier.
Havde intet at behandle med
Mange danskere kender måske især til problemet med antibiotikaresistens fra debatten om MRSA. MRSA er stafylokokbakterier, der er resistente over for en række forskellige typer antibiotika, som man ellers bruger til at behandle stafylokokinfektioner med.
- Problemerne med resistente tarmbakterier adskiller sig fra problemerne med MRSA på den måde, at der er tale om bakterier, som ellers regnes som vores gode tarmbakterier, siger Ulrik Stenz Justesen fra Klinisk Mikrobiologisk Afdeling på Odense Universitetshospital.
Læs mere på Videnskab.dk: Nyt, farligt resistensgen fundet i Danmark
- Vi har tusinder af milliarder af dem i tarmen, og vi kan ikke undvære dem. MRSA kan man groft sagt vaske af, men det kan man ikke med tarmbakterierne. Vi kan ikke slippe af med dem, fortsætter han.
Han har selv behandlet en patient, som fik blodforgiftning efter en operation. Blodforgiftningen skyldtes infektion med resistente tarmbakterier, og lægerne forsøgte forgæves at slå infektionen ned med forskellige typer antibiotika.
- Til sidst døde patienten, for vi havde intet tilbage, som vi kunne behandle ham med. Det var en meget voldsom historie, fortæller Ulrik Stenz Justesen.
En rigtig alvorlig situation
Heldigvis, siger han, er det de færreste danskere, der bærer rundt på multiresistente tarmbakterier - det vil sige, at bakterierne er resistente over for mange typer antibiotika.
Læs mere på Videnskab.dk: Kan antibiotikaresistens forsvinde?
- Her i Odense lavede vi en landsdækkende undersøgelse af, hvor mange patienter der får blodforgiftning med anaerobe (iltfrie, red.) tarmbakterier. Jeg samlede over 100 patienter ind på et halvt år. Ud af dem var 5-10 procent resistente over for livsvigtige antibiotika. Sådan er situationen lige nu, siger Ulrik Stenz Justesen og tilføjer:
- Men hvis vi fortsætter med at se den samme stigning i resistens blandt bakterier i tarmen, kan det ende med at blive en rigtig alvorlig situation.
Få adgang første måned for kun 49 kr.
Prøv Nordjyske nuAllerede abonnent? Log ind
Abonnementet giver adgang til Nordjyske.dk og fornyes automatisk til 109 kr. pr. måned og er uden binding.








